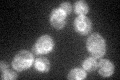
YDL128W
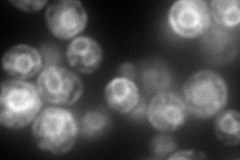
YDL128W
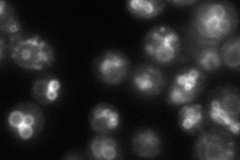
YDL128W
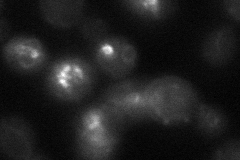
YDL128W
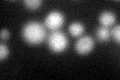
YDL128W
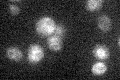
YDL128W

View description
Vacuolar H+/Ca2+ exchanger involved in control of cytosolic Ca2+ concentration; has similarity to sodium/calcium exchangers, including the bovine Na+/Ca2+,K+ antiporter
Localization:
Intensity:
Fold change:
Significance:
-
C’ GFP library in SD
ER40.55 -
N' NOP1pr-GFP in SD

vacuole membrane219.994 -
N' TEF2pr-mCherry in SD
ER276.246 -
N' NATIVEpr-GFP in SD
vacuole membrane70.9204 -
N' TEF2pr-VC and Cyto-VN in SD
punctate,vacuole membrane34.3453 -
C’ GFP library in SD+DTT
ER28.680.7No -
C’ GFP library in SD+H2O2

ER32.380.79No -
C’ GFP library in Starvation Media
ER22.90.56Yes -
C’ GFP library on the background of Pup2-DaMP

ER -
C’ GFP library on the background of CCT mutant

ER30.71330.75723No
